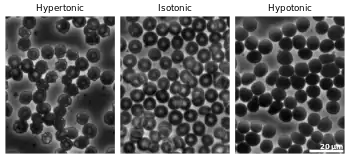

Red blood cell
| Red blood cells | |
|---|---|
 Scanning electron micrograph of human red blood cells (c. 6–8 μm in diameter) | |
| Details | |
| Function | Oxygen transport |
| Identifiers | |
| Acronym(s) | RBC |
| MeSH | D004912 |
| TH | H2.00.04.1.01001 |
| FMA | 62845 |
| Anatomical terms of microanatomy | |
Red blood cells (RBCs), scientific name erythrocytes (from ancient Greek erythros 'red' and kytos 'hollow vessel', with -cyte translated as 'cell' in modern usage), also known as red cells,[1] erythroid cells, and rarely haematids, are the most common type of blood cell and the vertebrate's principal means of delivering oxygen (O2) to the body tissues—via blood flow through the circulatory system.[2] Erythrocytes take up oxygen in the lungs, or in fish the gills, and release it into tissues while squeezing through the body's capillaries.
The cytoplasm of a red blood cell is rich in hemoglobin, an iron-containing biomolecule that can bind oxygen and is responsible for the red color of the cells and the blood. Each human red blood cell contains approximately 270 million hemoglobin molecules.[3] The cell membrane is composed of proteins and lipids, and this structure provides properties essential for physiological cell function such as deformability and stability of the blood cell while traversing the circulatory system and specifically the capillary network.
In humans, mature red blood cells are flexible biconcave disks. They lack a cell nucleus (which is expelled during development) and organelles, to accommodate maximum space for hemoglobin; they can be viewed as sacks of hemoglobin, with a plasma membrane as the sack. Approximately 2.4 million new erythrocytes are produced per second in human adults.[4] The cells develop in the bone marrow and circulate for about 100–120 days in the body before their components are recycled by macrophages. Each circulation takes about 60 seconds (one minute).[5] Approximately 84% of the cells in the human body are the 20–30 trillion red blood cells.[6][7][8][9] Nearly half of the blood's volume (40% to 45%) is red blood cells.
Packed red blood cells are red blood cells that have been donated, processed, and stored in a blood bank for blood transfusion.
Structure
Vertebrates


The vast majority of vertebrates, including mammals and humans, have red blood cells. Red blood cells are cells present in blood to transport oxygen. The only known vertebrates without red blood cells are the crocodile icefish (family Channichthyidae); they live in very oxygen-rich cold water and transport oxygen freely dissolved in their blood.[11] While they no longer use hemoglobin, remnants of hemoglobin genes can be found in their genome.[12]
Vertebrate red blood cells consist mainly of hemoglobin, a complex metalloprotein containing heme groups whose iron atoms temporarily bind to oxygen molecules (O2) in the lungs or gills and release them throughout the body. Oxygen can easily diffuse through the red blood cell's cell membrane. Hemoglobin in the red blood cells also carries some of the waste product carbon dioxide back from the tissues; most waste carbon dioxide, however, is transported back to the pulmonary capillaries of the lungs as bicarbonate (HCO3−) dissolved in the blood plasma. Myoglobin, a compound related to hemoglobin, acts to store oxygen in muscle cells.[13]
The color of red blood cells is due to the heme group of hemoglobin. The blood plasma alone is straw-colored, but the red blood cells change color depending on the state of the hemoglobin: when combined with oxygen the resulting oxyhemoglobin is scarlet, and when oxygen has been released the resulting deoxyhemoglobin is of a dark red burgundy color. However, blood can appear bluish when seen through the vessel wall and skin.[14] Pulse oximetry takes advantage of the hemoglobin color change to directly measure the arterial blood oxygen saturation using colorimetric techniques. Hemoglobin also has a very high affinity for carbon monoxide, forming carboxyhemoglobin which is a very bright red in color. Flushed, confused patients with a saturation reading of 100% on pulse oximetry are sometimes found to be suffering from carbon monoxide poisoning.
Having oxygen-carrying proteins inside specialized cells (as opposed to oxygen carriers being dissolved in body fluid) was an important step in the evolution of vertebrates as it allows for less viscous blood, higher concentrations of oxygen, and better diffusion of oxygen from the blood to the tissues. The size of red blood cells varies widely among vertebrate species; red blood cell width is on average about 25% larger than capillary diameter, and it has been hypothesized that this improves the oxygen transfer from red blood cells to tissues.[15]
Mammals

The red blood cells of mammals are typically shaped as biconcave disks: flattened and depressed in the center, with a dumbbell-shaped cross section, and a torus-shaped rim on the edge of the disk. This shape allows for a high surface-area-to-volume (SA/V) ratio to facilitate diffusion of gases.[16] However, there are some exceptions concerning shape in the artiodactyl order (even-toed ungulates including cattle, deer, and their relatives), which displays a wide variety of bizarre red blood cell morphologies: small and highly ovaloid cells in llamas and camels (family Camelidae), tiny spherical cells in mouse deer (family Tragulidae), and cells which assume fusiform, lanceolate, crescentic, and irregularly polygonal and other angular forms in red deer and wapiti (family Cervidae). Members of this order have clearly evolved a mode of red blood cell development substantially different from the mammalian norm.[10][17] Overall, mammalian red blood cells are remarkably flexible and deformable so as to squeeze through tiny capillaries, as well as to maximize their apposing surface by assuming a cigar shape, where they efficiently release their oxygen load.[18]
Red blood cells in mammals are unique amongst vertebrates as they do not have nuclei when mature. They do have nuclei during early phases of erythropoiesis, but extrude them during development as they mature; this provides more space for hemoglobin. The red blood cells without nuclei, called reticulocytes, subsequently lose all other cellular organelles such as their mitochondria, Golgi apparatus and endoplasmic reticulum.
The spleen acts as a reservoir of red blood cells, but this effect is somewhat limited in humans. In some other mammals such as dogs and horses, the spleen sequesters large numbers of red blood cells, which are dumped into the blood during times of exertion stress, yielding a higher oxygen transport capacity.

Human


A typical human red blood cell has a disk diameter of approximately 6.2–8.2 µm[19] and a thickness at the thickest point of 2–2.5 µm and a minimum thickness in the centre of 0.8–1 µm, being much smaller than most other human cells. These cells have an average volume of about 90 fL[20] with a surface area of about 136 μm2, and can swell up to a sphere shape containing 150 fL, without membrane distension.
Adult humans have roughly 20–30 trillion red blood cells at any given time, constituting approximately 70% of all cells by number.[21] Women have about 4–5 million red blood cells per microliter (cubic millimeter) of blood and men about 5–6 million; people living at high altitudes with low oxygen tension will have more. Red blood cells are thus much more common than the other blood particles: there are about 4,000–11,000 white blood cells and about 150,000–400,000 platelets per microliter.
Human red blood cells take on average 60 seconds to complete one cycle of circulation.[5][9][22]
The blood's red color is due to the spectral properties of the hemic iron ions in hemoglobin. Each hemoglobin molecule carries four heme groups; hemoglobin constitutes about a third of the total cell volume. Hemoglobin is responsible for the transport of more than 98% of the oxygen in the body (the remaining oxygen is carried dissolved in the blood plasma). The red blood cells of an average adult human male store collectively about 2.5 grams of iron, representing about 65% of the total iron contained in the body.[23][24]
Microstructure
Nucleus
Red blood cells in mammals are anucleate when mature, meaning that they lack a cell nucleus. In comparison, the red blood cells of other vertebrates have nuclei; the only known exceptions are salamanders of the family Plethodontidae, where five different clades has evolved various degrees of enucleated red blood cells (most evolved in some species of the genus Batrachoseps), and fish of the genus Maurolicus.[25][26][27]
The elimination of the nucleus in vertebrate red blood cells has been offered as an explanation for the subsequent accumulation of non-coding DNA in the genome.[17] The argument runs as follows: Efficient gas transport requires red blood cells to pass through very narrow capillaries, and this constrains their size. In the absence of nuclear elimination, the accumulation of repeat sequences is constrained by the volume occupied by the nucleus, which increases with genome size.
Nucleated red blood cells in mammals consist of two forms: normoblasts, which are normal erythropoietic precursors to mature red blood cells, and megaloblasts, which are abnormally large precursors that occur in megaloblastic anemias.
Membrane composition
Red blood cells are deformable, flexible, are able to adhere to other cells, and are able to interface with immune cells. Their membrane plays many roles in this. These functions are highly dependent on the membrane composition. The red blood cell membrane is composed of 3 layers: the glycocalyx on the exterior, which is rich in carbohydrates; the lipid bilayer which contains many transmembrane proteins, besides its lipidic main constituents; and the membrane skeleton, a structural network of proteins located on the inner surface of the lipid bilayer. Half of the membrane mass in human and most mammalian red blood cells are proteins. The other half are lipids, namely phospholipids and cholesterol.[28]
Membrane lipids

The red blood cell membrane comprises a typical lipid bilayer, similar to what can be found in virtually all human cells. Simply put, this lipid bilayer is composed of cholesterol and phospholipids in equal proportions by weight. The lipid composition is important as it defines many physical properties such as membrane permeability and fluidity. Additionally, the activity of many membrane proteins is regulated by interactions with lipids in the bilayer.
Unlike cholesterol, which is evenly distributed between the inner and outer leaflets, the 5 major phospholipids are asymmetrically disposed, as shown below:
Outer monolayer
- Phosphatidylcholine (PC);
- Sphingomyelin (SM).
Inner monolayer
- Phosphatidylethanolamine (PE);
- Phosphoinositol (PI) (small amounts).
- Phosphatidylserine (PS);
This asymmetric phospholipid distribution among the bilayer is the result of the function of several energy-dependent and energy-independent phospholipid transport proteins. Proteins called "Flippases" move phospholipids from the outer to the inner monolayer, while others called "floppases" do the opposite operation, against a concentration gradient in an energy-dependent manner. Additionally, there are also "scramblase" proteins that move phospholipids in both directions at the same time, down their concentration gradients in an energy-independent manner. There is still considerable debate ongoing regarding the identity of these membrane maintenance proteins in the red cell membrane.
The maintenance of an asymmetric phospholipid distribution in the bilayer (such as an exclusive localization of PS and PIs in the inner monolayer) is critical for the cell integrity and function due to several reasons:
- Macrophages recognize and phagocytose red cells that expose PS at their outer surface. Thus the confinement of PS in the inner monolayer is essential if the cell is to survive its frequent encounters with macrophages of the reticuloendothelial system, especially in the spleen.
- Premature destruction of thallassemic and sickle red cells has been linked to disruptions of lipid asymmetry leading to exposure of PS on the outer monolayer.
- An exposure of PS can potentiate adhesion of red cells to vascular endothelial cells, effectively preventing normal transit through the microvasculature. Thus it is important that PS is maintained only in the inner leaflet of the bilayer to ensure normal blood flow in microcirculation.
- Both PS and phosphatidylinositol 4,5-bisphosphate (PIP2) can regulate membrane mechanical function, due to their interactions with skeletal proteins such as spectrin and protein 4.1R. Recent studies have shown that binding of spectrin to PS promotes membrane mechanical stability. PIP2 enhances the binding of protein band 4.1R to glycophorin C but decreases its interaction with protein band 3, and thereby may modulate the linkage of the bilayer to the membrane skeleton.
The presence of specialized structures named "lipid rafts" in the red blood cell membrane have been described by recent studies. These are structures enriched in cholesterol and sphingolipids associated with specific membrane proteins, namely flotillins, STOMatins (band 7), G-proteins, and β-adrenergic receptors. Lipid rafts that have been implicated in cell signaling events in nonerythroid cells have been shown in erythroid cells to mediate β2-adregenic receptor signaling and increase cAMP levels, and thus regulating entry of malarial parasites into normal red cells.[29][30]
Membrane proteins
The proteins of the membrane skeleton are responsible for the deformability, flexibility and durability of the red blood cell, enabling it to squeeze through capillaries less than half the diameter of the red blood cell (7–8 μm) and recovering the discoid shape as soon as these cells stop receiving compressive forces, in a similar fashion to an object made of rubber.
There are currently more than 50 known membrane proteins, which can exist in a few hundred up to a million copies per red blood cell. Approximately 25 of these membrane proteins carry the various blood group antigens, such as the A, B and Rh antigens, among many others. These membrane proteins can perform a wide diversity of functions, such as transporting ions and molecules across the red cell membrane, adhesion and interaction with other cells such as endothelial cells, as signaling receptors, as well as other currently unknown functions. The blood types of humans are due to variations in surface glycoproteins of red blood cells. Disorders of the proteins in these membranes are associated with many disorders, such as hereditary spherocytosis, hereditary elliptocytosis, hereditary stomatocytosis, and paroxysmal nocturnal hemoglobinuria.[28][29]
The red blood cell membrane proteins organized according to their function:

Transport
- Band 3 – Anion transporter, also an important structural component of the red blood cell membrane, makes up to 25% of the cell membrane surface, each red cell contains approximately one million copies. Defines the Diego Blood Group;[32]
- Aquaporin 1 – water transporter, defines the Colton Blood Group;
- Glut1 – glucose and L-dehydroascorbic acid transporter;
- MCT1 – Monocarboxylate transporter for exporting Lactic acid to the liver. See Cori cycle.;[33]
- Kidd antigen protein – urea transporter;
- RHAG – gas transporter, probably of carbon dioxide, defines Rh Blood Group and the associated unusual blood group phenotype Rhnull;
- Na+/K+ – ATPase;
- Ca2+ – ATPase;
- Na+ K+ 2Cl− – cotransporter;
- Na+-Cl− – cotransporter;
- Na-H exchanger;
- K-Cl – cotransporter;
- Gardos Channel.
Cell adhesion
- ICAM-4 – interacts with integrins;
- BCAM – a glycoprotein that defines the Lutheran blood group and also known as Lu or laminin-binding protein.
Structural role – The following membrane proteins establish linkages with skeletal proteins and may play an important role in regulating cohesion between the lipid bilayer and membrane skeleton, likely enabling the red cell to maintain its favorable membrane surface area by preventing the membrane from collapsing (vesiculating).
- Ankyrin-based macromolecular complex – proteins linking the bilayer to the membrane skeleton through the interaction of their cytoplasmic domains with Ankyrin.
- Band 3 – also assembles various glycolytic enzymes, the presumptive CO2 transporter, and carbonic anhydrase into a macromolecular complex termed a "metabolon," which may play a key role in regulating red cell metabolism and ion and gas transport function.
- RHAG – also involved in transport, defines associated unusual blood group phenotype Rhmod.
- Protein 4.1R-based macromolecular complex – proteins interacting with Protein 4.1R.
- Protein 4.1R – weak expression of Gerbich antigens;
- Glycophorin C and D – glycoprotein, defines Gerbich Blood Group;
- XK – defines the Kell Blood Group and the Mcleod unusual phenotype (lack of Kx antigen and greatly reduced expression of Kell antigens);
- RhD/RhCE – defines Rh Blood Group and the associated unusual blood group phenotype Rhnull;
- Duffy protein – has been proposed to be associated with chemokine clearance;[34]
- Adducin – interaction with band 3;
- Dematin- interaction with the Glut1 glucose transporter.
Surface electrostatic potential
The zeta potential is an electrochemical property of cell surfaces that is determined by the net electrical charge of molecules exposed at the surface of cell membranes of the cell. The normal zeta potential of the red blood cell is −15.7 millivolts (mV).[35] Much of this potential appears to be contributed by the exposed sialic acid residues in the membrane: their removal results in zeta potential of −6.06 mV.
Function
Role in CO2 transport
Recall that respiration, as illustrated schematically here with a unit of carbohydrate, produces about as many molecules of carbon dioxide, CO2, as it consumes of oxygen, O2.[36]
Thus, the function of the circulatory system is as much about the transport of carbon dioxide as about the transport of oxygen. As stated elsewhere in this article, most of the carbon dioxide in the blood is in the form of bicarbonate ion. The bicarbonate provides a critical pH buffer.[37] Thus, unlike hemoglobin for O2 transport, there is a physiological advantage to not having a specific CO2 transporter molecule.
Red blood cells, nevertheless, play a key role in the CO2 transport process, for two reasons. First, because, besides hemoglobin, they contain a large number of copies of the enzyme carbonic anhydrase on the inside of their cell membrane.[38] Carbonic anhydrase, as its name suggests, acts as a catalyst of the exchange between carbonic acid and carbon dioxide (which is the anhydride of carbonic acid). Because it is a catalyst, it can affect many CO2 molecules, so it performs its essential role without needing as many copies as are needed for O2 transport by hemoglobin. In the presence of this catalyst carbon dioxide and carbonic acid reach an equilibrium very rapidly, while the red cells are still moving through the capillary. Thus it is the RBC that ensures that most of the CO2 is transported as bicarbonate.[39][40] At physiological pH the equilibrium strongly favors carbonic acid, which is mostly dissociated into bicarbonate ion.[41]
The H+ ions released by this rapid reaction within RBC, while still in the capillary, act to reduce the oxygen binding affinity of hemoglobin, the Bohr effect.
The second major contribution of RBC to carbon dioxide transport is that carbon dioxide directly reacts with globin protein components of hemoglobin to form carbaminohemoglobin compounds. As oxygen is released in the tissues, more CO2 binds to hemoglobin, and as oxygen binds in the lung, it displaces the hemoglobin bound CO2, this is called the Haldane effect. Despite the fact that only a small amount of the CO2 in blood is bound to hemoglobin in venous blood, a greater proportion of the change in CO2 content between venous and arterial blood comes from the change in this bound CO2.[42] That is, there is always an abundance of bicarbonate in blood, both venous and arterial, because of its aforementioned role as a pH buffer.
In summary, carbon dioxide produced by cellular respiration diffuses very rapidly to areas of lower concentration, specifically into nearby capillaries.[43][44] When it diffuses into a RBC, CO2 is rapidly converted by the carbonic anhydrase found on the inside of the RBC membrane into bicarbonate ion. The bicarbonate ions in turn leave the RBC in exchange for chloride ions from the plasma, facilitated by the band 3 anion transport protein colocated in the RBC membrane. The bicarbonate ion does not diffuse back out of the capillary, but is carried to the lung. In the lung the lower partial pressure of carbon dioxide in the alveoli causes carbon dioxide to diffuse rapidly from the capillary into the alveoli. The carbonic anhydrase in the red cells keeps the bicarbonate ion in equilibrium with carbon dioxide. So as carbon dioxide leaves the capillary, and CO2 is displaced by O2 on hemoglobin, sufficient bicarbonate ion converts rapidly to carbon dioxide to maintain the equilibrium.[38][45][46][47]
Secondary functions
When red blood cells undergo shear stress in constricted vessels, they release ATP, which causes the vessel walls to relax and dilate so as to promote normal blood flow.[48]
When their hemoglobin molecules are deoxygenated, red blood cells release S-Nitrosothiols, which also act to dilate blood vessels,[49] thus directing more blood to areas of the body depleted of oxygen.
Red blood cells can also synthesize nitric oxide enzymatically, using L-arginine as substrate, as do endothelial cells.[50] Exposure of red blood cells to physiological levels of shear stress activates nitric oxide synthase and export of nitric oxide,[51] which may contribute to the regulation of vascular tonus.
Red blood cells can also produce hydrogen sulfide, a signalling gas that acts to relax vessel walls. It is believed that the cardioprotective effects of garlic are due to red blood cells converting its sulfur compounds into hydrogen sulfide.[52]
Red blood cells also play a part in the body's immune response: when lysed by pathogens such as bacteria, their hemoglobin releases free radicals, which break down the pathogen's cell wall and membrane, killing it.[53][54]
Cellular processes
As a result of not containing mitochondria, red blood cells use none of the oxygen they transport; instead they produce the energy carrier ATP by the glycolysis of glucose and lactic acid fermentation on the resulting pyruvate.[55][56] Furthermore, the pentose phosphate pathway plays an important role in red blood cells; see glucose-6-phosphate dehydrogenase deficiency for more information.
As red blood cells contain no nucleus, protein biosynthesis is currently assumed to be absent in these cells.
Because of the lack of nuclei and organelles, mature red blood cells do not contain DNA and cannot synthesize any RNA (although it does contain RNAs),[57][58] and consequently cannot divide and have limited repair capabilities.[59] The inability to carry out protein synthesis means that no virus can evolve to target mammalian red blood cells.[60] However, infection with parvoviruses (such as human parvovirus B19) can affect erythroid precursors while they still have DNA, as recognized by the presence of giant pronormoblasts with viral particles and inclusion bodies, thus temporarily depleting the blood of reticulocytes and causing anemia.[61]
Life cycle
Human red blood cells are produced through a process named erythropoiesis, developing from committed stem cells to mature red blood cells in about 7 days. When matured, in a healthy individual these cells live in blood circulation for about 100 to 120 days (and 80 to 90 days in a full term infant).[62] At the end of their lifespan, they are removed from circulation. In many chronic diseases, the lifespan of the red blood cells is reduced.
Creation
Erythropoiesis is the process by which new red blood cells are produced; it lasts about 7 days. Through this process red blood cells are continuously produced in the red bone marrow of large bones. (In the embryo, the liver is the main site of red blood cell production.) The production can be stimulated by the hormone erythropoietin (EPO), synthesised by the kidney. Just before and after leaving the bone marrow, the developing cells are known as reticulocytes; these constitute about 1% of circulating red blood cells.
Functional lifetime
The functional lifetime of a red blood cell is about 100–120 days, during which time the red blood cells are continually moved by the blood flow push (in arteries), pull (in veins) and a combination of the two as they squeeze through microvessels such as capillaries. They are also recycled in the bone marrow.[63]
Senescence
The aging red blood cell undergoes changes in its plasma membrane, making it susceptible to selective recognition by macrophages and subsequent phagocytosis in the mononuclear phagocyte system (spleen, liver and lymph nodes), thus removing old and defective cells and continually purging the blood. This process is termed eryptosis, red blood cell programmed death.[64] This process normally occurs at the same rate of production by erythropoiesis, balancing the total circulating red blood cell count. Eryptosis is increased in a wide variety of diseases including sepsis, haemolytic uremic syndrome, malaria, sickle cell anemia, beta-thalassemia, glucose-6-phosphate dehydrogenase deficiency, phosphate depletion, iron deficiency and Wilson's disease. Eryptosis can be elicited by osmotic shock, oxidative stress, and energy depletion, as well as by a wide variety of endogenous mediators and xenobiotics. Excessive eryptosis is observed in red blood cells lacking the cGMP-dependent protein kinase type I or the AMP-activated protein kinase AMPK. Inhibitors of eryptosis include erythropoietin, nitric oxide, catecholamines and high concentrations of urea.
Much of the resulting breakdown products are recirculated in the body. The heme constituent of hemoglobin are broken down into iron (Fe3+) and biliverdin. The biliverdin is reduced to bilirubin, which is released into the plasma and recirculated to the liver bound to albumin. The iron is released into the plasma to be recirculated by a carrier protein called transferrin. Almost all red blood cells are removed in this manner from the circulation before they are old enough to hemolyze. Hemolyzed hemoglobin is bound to a protein in plasma called haptoglobin, which is not excreted by the kidney.[65]
Clinical significance
Disease

Blood diseases involving the red blood cells include:
- Anemias (or anaemias) are diseases characterized by low oxygen transport capacity of the blood, because of low red cell count or some abnormality of the red blood cells or the hemoglobin.
- Iron deficiency anemia is the most common anemia; it occurs when the dietary intake or absorption of iron is insufficient, and hemoglobin, which contains iron, cannot be formed.
- Pernicious anemia is an autoimmune disease wherein the body lacks intrinsic factor, required to absorb vitamin B12 from food. Vitamin B12 is needed for the production of red blood cells and hemoglobin.
- Sickle-cell disease is a genetic disease that results in abnormal hemoglobin molecules. When these release their oxygen load in the tissues, they become insoluble, leading to mis-shaped red blood cells. These sickle shaped red cells are less deformable and viscoelastic, meaning that they have become rigid and can cause blood vessel blockage, pain, strokes, and other tissue damage.
- Thalassemia is a genetic disease that results in the production of an abnormal ratio of hemoglobin subunits.
- Hereditary spherocytosis syndromes are a group of inherited disorders characterized by defects in the red blood cell's cell membrane, causing the cells to be small, sphere-shaped, and fragile instead of donut-shaped and flexible. These abnormal red blood cells are destroyed by the spleen. Several other hereditary disorders of the red blood cell membrane are known.[66]
- Aplastic anemia is caused by the inability of the bone marrow to produce blood cells.
- Pure red cell aplasia is caused by the inability of the bone marrow to produce only red blood cells.

- Hemolysis is the general term for excessive breakdown of red blood cells. It can have several causes and can result in hemolytic anemia.
- The malaria parasite spends part of its life-cycle in red blood cells, feeds on their hemoglobin and then breaks them apart, causing fever. Both sickle-cell disease and thalassemia are more common in malaria areas, because these mutations convey some protection against the parasite.
- Polycythemias (or erythrocytoses) are diseases characterized by a surplus of red blood cells. The increased viscosity of the blood can cause a number of symptoms.
- In polycythemia vera the increased number of red blood cells results from an abnormality in the bone marrow.
- Several microangiopathic diseases, including disseminated intravascular coagulation and thrombotic microangiopathies, present with pathognomonic (diagnostic) red blood cell fragments called schistocytes. These pathologies generate fibrin strands that sever red blood cells as they try to move past a thrombus.
Transfusion
Red blood cells may be given as part of a blood transfusion. Blood may be donated from another person, or stored by the recipient at an earlier date. Donated blood usually requires screening to ensure that donors do not contain risk factors for the presence of blood-borne diseases, or will not suffer themselves by giving blood. Blood is usually collected and tested for common or serious blood-borne diseases including Hepatitis B, Hepatitis C and HIV. The blood type (A, B, AB, or O) or the blood product is identified and matched with the recipient's blood to minimise the likelihood of acute hemolytic transfusion reaction, a type of transfusion reaction. This relates to the presence of antigens on the cell's surface. After this process, the blood is stored, and within a short duration is used. Blood can be given as a whole product or the red blood cells separated as packed red blood cells.
Blood is often transfused when there is known anaemia, active bleeding, or when there is an expectation of serious blood loss, such as prior to an operation. Before blood is given, a small sample of the recipient's blood is tested with the transfusion in a process known as cross-matching.
In 2008 it was reported that human embryonic stem cells had been successfully coaxed into becoming red blood cells in the lab. The difficult step was to induce the cells to eject their nucleus; this was achieved by growing the cells on stromal cells from the bone marrow. It is hoped that these artificial red blood cells can eventually be used for blood transfusions.[67]
A human trial is conducted in 2022, using blood cultured from stem cells obtained from donor blood.[68]
Tests

Several blood tests involve red blood cells. These include a RBC count (the number of red blood cells per volume of blood), calculation of the hematocrit (percentage of blood volume occupied by red blood cells), and the erythrocyte sedimentation rate. The blood type needs to be determined to prepare for a blood transfusion or an organ transplantation.
Many diseases involving red blood cells are diagnosed with a blood film (or peripheral blood smear), where a thin layer of blood is smeared on a microscope slide. This may reveal poikilocytosis, which are variations in red blood cell shape. When red blood cells sometimes occur as a stack, flat side next to flat side. This is known as rouleaux formation, and it occurs more often if the levels of certain serum proteins are elevated, as for instance during inflammation.
Separation and blood doping
Red blood cells can be obtained from whole blood by centrifugation, which separates the cells from the blood plasma in a process known as blood fractionation. Packed red blood cells, which are made in this way from whole blood with the plasma removed, are used in transfusion medicine.[69] During plasma donation, the red blood cells are pumped back into the body right away and only the plasma is collected.
Some athletes have tried to improve their performance by blood doping: first about 1 litre of their blood is extracted, then the red blood cells are isolated, frozen and stored, to be reinjected shortly before the competition. (Red blood cells can be conserved for 5 weeks at −79 °C or −110 °F, or over 10 years using cryoprotectants[70]) This practice is hard to detect but may endanger the human cardiovascular system which is not equipped to deal with blood of the resulting higher viscosity. Another method of blood doping involves injection with erythropoietin to stimulate production of red blood cells. Both practices are banned by the World Anti-Doping Agency.
History
The first person to describe red blood cells was the young Dutch biologist Jan Swammerdam, who had used an early microscope in 1658 to study the blood of a frog.[71] Unaware of this work, Anton van Leeuwenhoek provided another microscopic description in 1674, this time providing a more precise description of red blood cells, even approximating their size, "25,000 times smaller than a fine grain of sand".
In the 1740s, Vincenzo Menghini in Bologna was able to demonstrate the presence of iron by passing magnets over the powder or ash remaining from heated red blood cells.
In 1901, Karl Landsteiner published his discovery of the three main blood groups—A, B, and C (which he later renamed to O). Landsteiner described the regular patterns in which reactions occurred when serum was mixed with red blood cells, thus identifying compatible and conflicting combinations between these blood groups. A year later Alfred von Decastello and Adriano Sturli, two colleagues of Landsteiner, identified a fourth blood group—AB.
In 1959, by use of X-ray crystallography, Max Perutz was able to unravel the structure of hemoglobin, the red blood cell protein that carries oxygen.[72]
The oldest intact red blood cells ever discovered were found in Ötzi the Iceman, a natural mummy of a man who died around 3255 BCE. These cells were discovered in May 2012.[73]
See also
References
- ↑ Kumar V, Abbas AK, Fausto N, Mitchell RN (2007). Robbins Basic Pathology (8th ed.). Saunders.
- ↑ "Blood Cells". Archived from the original on 23 July 2016.
- ↑ D'Alessandro A, Dzieciatkowska M, Nemkov T, Hansen KC (March 2017). "Red blood cell proteomics update: is there more to discover?". Blood Transfusion = Trasfusione del Sangue. 15 (2): 182–187. doi:10.2450/2017.0293-16. PMC 5336341. PMID 28263177.
- ↑ Erich Sackmann, Biological Membranes Architecture and Function., Handbook of Biological Physics, (ed. R.Lipowsky and E.Sackmann, vol.1, Elsevier, 1995
- 1 2 Blom JA (2003). Monitoring of Respiration and Circulation. CRC Press. p. 27. ISBN 978-0-203-50328-7.
- ↑ Hatton IA, Galbraith ED, Merleau NS, Miettinen TP, Smith BM, Shander JA (September 2023). "The human cell count and size distribution". Proceedings of the National Academy of Sciences of the United States of America. 120 (39): e2303077120. Bibcode:2023PNAS..12003077H. doi:10.1073/pnas.2303077120. PMC 10523466. PMID 37722043.
- ↑ Sender R, Fuchs S, Milo R (August 2016). "Revised Estimates for the Number of Human and Bacteria Cells in the Body". PLOS Biology. 14 (8): e1002533. doi:10.1371/journal.pbio.1002533. PMC 4991899. PMID 27541692.
- ↑ Dean L (2005). Blood Groups and Red Cell Antigens. National Center for Biotechnology Information (US).
- 1 2 Pierigè F, Serafini S, Rossi L, Magnani M (January 2008). "Cell-based drug delivery". Advanced Drug Delivery Reviews. 60 (2): 286–295. doi:10.1016/j.addr.2007.08.029. PMID 17997501.
- 1 2 Gulliver G (1875). "On the size and shape of red corpuscles of the blood of vertebrates, with drawings of them to a uniform scale, and extended and revised tables of measurements". Proceedings of the Zoological Society of London. 1875: 474–495.
- ↑ Ruud JT (May 1954). "Vertebrates without erythrocytes and blood pigment". Nature. 173 (4410): 848–850. Bibcode:1954Natur.173..848R. doi:10.1038/173848a0. PMID 13165664. S2CID 3261779.
- ↑ Carroll S (2006). The Making of the Fittest. W.W. Norton. ISBN 978-0-393-06163-5.
- ↑ Maton A, Hopkins J, McLaughlin CW, Johnson S, Warner MQ, LaHart D, Wright JD (1993). Human Biology and Health. Englewood Cliffs, New Jersey: Prentice Hall. ISBN 978-0-13-981176-0.
- ↑ Anthis N (17 April 2008). "Why Are Veins Blue?". Scienceblogs. Retrieved 23 April 2015.
- ↑ Snyder GK, Sheafor BA (1999). "Red Blood Cells: Centerpiece in the Evolution of the Vertebrate Circulatory System". Integrative and Comparative Biology. 39 (2): 189–198. doi:10.1093/icb/39.2.189.
- ↑ "BBC Bitesize – GCSE Biology – Blood – Revision 2". www.bbc.co.uk. Retrieved 26 November 2017.
- 1 2 Gregory TR (2001). "The bigger the C-value, the larger the cell: genome size and red blood cell size in vertebrates". Blood Cells, Molecules & Diseases. 27 (5): 830–843. CiteSeerX 10.1.1.22.9555. doi:10.1006/bcmd.2001.0457. PMID 11783946.
- ↑ Goodman SR, Kurdia A, Ammann L, Kakhniashvili D, Daescu O (December 2007). "The human red blood cell proteome and interactome". Experimental Biology and Medicine. 232 (11): 1391–1408. doi:10.3181/0706-MR-156. PMID 18040063. S2CID 32326166.
- ↑ Turgeon ML (2004). Clinical Hematology: Theory and Procedures. Lippincott Williams & Wilkins. p. 100. ISBN 9780781750073.
- ↑ McLaren CE, Brittenham GM, Hasselblad V (April 1987). "Statistical and graphical evaluation of erythrocyte volume distributions". The American Journal of Physiology. 252 (4 Pt 2): H857–H866. CiteSeerX 10.1.1.1000.348. doi:10.1152/ajpheart.1987.252.4.H857. PMID 3565597.
- ↑ Bianconi E, Piovesan A, Facchin F, Beraudi A, Casadei R, Frabetti F, et al. (1 November 2013). "An estimation of the number of cells in the human body". Annals of Human Biology. 40 (6): 463–471. doi:10.3109/03014460.2013.807878. hdl:11585/152451. PMID 23829164. S2CID 16247166.
- ↑ Hillman RS, Ault KA, Rinder HM (2005). Hematology in Clinical Practice: A Guide to Diagnosis and Management (4th ed.). McGraw-Hill Professional. p. 1. ISBN 978-0-07-144035-6.
- ↑ Iron Metabolism, University of Virginia Pathology. Accessed 22 September 2007.
- ↑ Bridges KR. "Transferrin and Iron Transport Physiology". Information Center for Sickle Cell and Thalassemic Disorders. Retrieved 26 March 2023.
- ↑ Cohen WD (1982). "The cytomorphic system of anucleate non-mammalian erythrocytes". Protoplasma. 113: 23–32. doi:10.1007/BF01283036. S2CID 41287948.
- ↑ Wingstrand KG (1956). "Non-nucleated erythrocytes in a teleostean fish Maurolicus mülleri (Gmelin)". Zeitschrift für Zellforschung und Mikroskopische Anatomie. 45 (2): 195–200. doi:10.1007/BF00338830. PMID 13402080. S2CID 12916049.
- ↑ Genome size, cell size, and the evolution of enucleated erythrocytes in attenuate salamanders
- 1 2 3 Yazdanbakhsh K, Lomas-Francis C, Reid ME (October 2000). "Blood groups and diseases associated with inherited abnormalities of the red blood cell membrane". Transfusion Medicine Reviews. 14 (4): 364–374. doi:10.1053/tmrv.2000.16232. PMID 11055079.
- 1 2 3 Mohandas N, Gallagher PG (November 2008). "Red cell membrane: past, present, and future". Blood. 112 (10): 3939–3948. doi:10.1182/blood-2008-07-161166. PMC 2582001. PMID 18988878.
- ↑ Rodi PM, Trucco VM, Gennaro AM (June 2008). "Factors determining detergent resistance of erythrocyte membranes". Biophysical Chemistry. 135 (1–3): 14–18. doi:10.1016/j.bpc.2008.02.015. hdl:11336/24825. PMID 18394774.
- ↑ Hempelmann E, Götze O (1984). "Characterization of membrane proteins by polychromatic silver staining". Hoppe-Seyler's Z Physiol Chem. 365: 241–42.
- ↑ Iolascon A, Perrotta S, Stewart GW (March 2003). "Red blood cell membrane defects". Reviews in Clinical and Experimental Hematology. 7 (1): 22–56. PMID 14692233.
- ↑ Fisel P, Schaeffeler E, Schwab M (July 2018). "Clinical and Functional Relevance of the Monocarboxylate Transporter Family in Disease Pathophysiology and Drug Therapy". Clinical and Translational Science. 11 (4): 352–364. doi:10.1111/cts.12551. PMC 6039204. PMID 29660777.
- ↑ Denomme GA (July 2004). "The structure and function of the molecules that carry human red blood cell and platelet antigens". Transfusion Medicine Reviews. 18 (3): 203–231. doi:10.1016/j.tmrv.2004.03.006. PMID 15248170.
- ↑ Tokumasu F, Ostera GR, Amaratunga C, Fairhurst RM (2012) Modifications in erythrocyte membrane zeta potential by Plasmodium falciparum infection. Exp Parasitol
- ↑ Guyton AC (1976). "Ch. 41 Transport of Oxygen and Carbon Dioxide in the Blood and Body Fluids". Textbook of Medical Physiology (Fifth ed.). Philadelphia, PA: W. B. Saunders. p. 556. ISBN 0-7216-4393-0.
The Respiratory Exchange Ratio is 1:1 when carbohydrate is consumed, it is as low as 0.7 when fat is consumed.
- ↑ West JB (1974). "Gas Transport to the Periphery". Respiratory Physiology – the essentials. Baltimore, MD: Williams & Wilkens. p. 80. ISBN 0-683-08932-3.
Acid Base Status: The transport of CO2 has a profound effect on the acid-base status of blood and the body as a whole. The lung excretes over 10,000 mEq of carbonic acid per day compared to less than 100 mEq of fixed acids by the kidney.
- 1 2 Guyton AC (1976). "Ch. 41 Transport of Oxygen and Carbon Dioxide in the Blood and Body Fluids". Textbook of Medical Physiology (Fifth ed.). Philadelphia, PA: W. B. Saunders. pp. 553–554. ISBN 0-7216-4393-0.
Reaction of Carbon Dioxide with Water in the Red Blood Cells - Effect of Carbonic Anhydrase
- ↑ Guyton AC (1976). "Ch. 41 Transport of Oxygen and Carbon Dioxide in the Blood and Body Fluids". Textbook of Medical Physiology (Fifth ed.). Philadelphia, PA: W. B. Saunders. pp. 553–554. ISBN 0-7216-4393-0.
carbonic anhydrase catalyzes the reaction between carbon dioxide and water.
- ↑ Comroe Jr JH (1965). "Transport and elimination of carbon dioxide". Physiology of Respiration (1971 ed.). Chicago, IL: Year Book Medical Publishers. p. 176. ISBN 0-8151-1824-4.
[carbonic anhdrase] makes the reaction go to the right about 13000 times as fast
- ↑ Diem K, Lentner C, eds. (1970). "Blood Gasses". Documenta Geigy Scientific Tables (7th ed.). Basle, Switzerland: Ciba-Geigy Limited. pp. 570–571.
In plasma about 5% of CO2 is in physical solution 94% as bicarbonate and 1% as carbamino compounds; in the erythrocytes the corresponding figures are 7%, 82% and 11%.
- ↑ Guyton AC (1976). "Ch. 41 Transport of Oxygen and Carbon Dioxide in the Blood and Body Fluids". Textbook of Medical Physiology (Fifth ed.). Philadelphia, PA: W. B. Saunders. p. 554. ISBN 0-7216-4393-0.
from figure 41-5 Hgb.CO2 is about 23% and bicarbonate is about 70% of the total carbon dioxide transported to the lungs.
- ↑ Comroe J (1965). "Pulmonary Gas Diffusion". Physiology of Respiration (1971 ed.). Chicago, IL: Year Book Medical Publishers. p. 140. ISBN 0-8151-1824-4.
Despite being a heavier molecule, because it is more soluble, the relative rate of diffusion of CO2 is about 20 times the rate of O2
- ↑ Guyton AC (1976). "Ch. 41 Transport of Oxygen and Carbon Dioxide in the Blood and Body Fluids". Textbook of Medical Physiology (Fifth ed.). Philadelphia, PA: W. B. Saunders. p. 553. ISBN 0-7216-4393-0.
carbon dioxide diffuses out of the tissue cells in the gaseous form (but not to a significant effect in the bicarbonate form because the cell membrane is far less permeable to bicarbonate than to the dissolved gas.
- ↑ Comroe Jr JH (1965). "Transport and elimination of carbon dioxide". Physiology of Respiration (1971 ed.). Chicago, IL: Year Book Medical Publishers. pp. 175–177. ISBN 0-8151-1824-4.
the buffering occurred in the red cell
- ↑ West JB (1974). "Gas Transport to the Periphery". Respiratory Physiology – the essentials. Baltimore, MD: Williams & Wilkens. pp. 77–79. ISBN 0-683-08932-3.
CO2 Transport
- ↑ Stone WE (1973). "Ch. 6-1 Uptake and Delivery of the Respiratory Gasses". In Brobeck JR (ed.). Best & Taylor's Physiological basis of medical practice (9th ed.). Baltimore, MD: Williams & Wilkins. pp. 6.16–6.18. ISBN 0-683-10160-9.
Transport of CO2 as Bicarbonate
- ↑ Wan J, Ristenpart WD, Stone HA (October 2008). "Dynamics of shear-induced ATP release from red blood cells". Proceedings of the National Academy of Sciences of the United States of America. 105 (43): 16432–16437. Bibcode:2008PNAS..10516432W. doi:10.1073/pnas.0805779105. PMC 2575437. PMID 18922780.
- ↑ Diesen DL, Hess DT, Stamler JS (August 2008). "Hypoxic vasodilation by red blood cells: evidence for an s-nitrosothiol-based signal". Circulation Research. 103 (5): 545–553. doi:10.1161/CIRCRESAHA.108.176867. PMC 2763414. PMID 18658051.
- ↑ Kleinbongard P, Schulz R, Rassaf T, Lauer T, Dejam A, Jax T, et al. (April 2006). "Red blood cells express a functional endothelial nitric oxide synthase". Blood. 107 (7): 2943–2951. doi:10.1182/blood-2005-10-3992. PMID 16368881. S2CID 38270024.
- ↑ Ulker P, Sati L, Celik-Ozenci C, Meiselman HJ, Baskurt OK (2009). "Mechanical stimulation of nitric oxide synthesizing mechanisms in erythrocytes". Biorheology. 46 (2): 121–132. doi:10.3233/BIR-2009-0532. PMID 19458415.
- ↑ Benavides GA, Squadrito GL, Mills RW, Patel HD, Isbell TS, Patel RP, et al. (November 2007). "Hydrogen sulfide mediates the vasoactivity of garlic". Proceedings of the National Academy of Sciences of the United States of America. 104 (46): 17977–17982. Bibcode:2007PNAS..10417977B. doi:10.1073/pnas.0705710104. PMC 2084282. PMID 17951430.
- ↑ Kesava S (1 September 2007). "Red blood cells do more than just carry oxygen; New findings by NUS team show they aggressively attack bacteria too" (PDF). The Straits Times. Retrieved 26 March 2013.
- ↑ Jiang N, Tan NS, Ho B, Ding JL (October 2007). "Respiratory protein-generated reactive oxygen species as an antimicrobial strategy". Nature Immunology. 8 (10): 1114–1122. doi:10.1038/ni1501. PMID 17721536. S2CID 11359246.
- ↑ Berg JM, Tymoczko JL, Stryer L (2012). Biochemistry (7th ed.). New York: W.H. Freeman. pp. 455, 609. ISBN 9781429229364.
- ↑ Tilton WM, Seaman C, Carriero D, Piomelli S (August 1991). "Regulation of glycolysis in the erythrocyte: role of the lactate/pyruvate and NAD/NADH ratios". The Journal of Laboratory and Clinical Medicine. 118 (2): 146–152. PMID 1856577.
- ↑ Kabanova S, Kleinbongard P, Volkmer J, Andrée B, Kelm M, Jax TW (2009). "Gene expression analysis of human red blood cells". International Journal of Medical Sciences. 6 (4): 156–159. doi:10.7150/ijms.6.156. PMC 2677714. PMID 19421340.
- ↑ Jain V, Yang WH, Wu J, Roback JD, Gregory SG, Chi JT (2022). "Single Cell RNA-Seq Analysis of Human Red Cells". Frontiers in Physiology. 13: 828700. doi:10.3389/fphys.2022.828700. PMC 9065680. PMID 35514346.
- ↑ Alberts, Bruce; Johnson, Alexander; Lewis, Julian; Raff, Martin; Roberts, Keith; Walter, Peter (2002). "Erythropoiesis Depends on the Hormone Erythropoietin". Molecular biology of the cell (4th ed.). New York: Garland. ISBN 0-8153-4072-9. Retrieved 30 November 2023.
- ↑ Zimmer C (27 March 2007). "Scientists Explore Ways to Lure Viruses to Their Death". The New York Times. Retrieved 26 March 2013.
- ↑ Heegaard ED, Brown KE (July 2002). "Human parvovirus B19". Clinical Microbiology Reviews. 15 (3): 485–505. doi:10.1128/CMR.15.3.485-505.2002. PMC 118081. PMID 12097253.
- ↑ Harrison KL (June 1979). "Fetal erythrocyte lifespan". Australian Paediatric Journal. 15 (2): 96–97. doi:10.1111/j.1440-1754.1979.tb01197.x. PMID 485998. S2CID 5370064.
- ↑ Higgins JM (March 2015). "Red blood cell population dynamics". Clinics in Laboratory Medicine. 35 (1): 43–57. doi:10.1016/j.cll.2014.10.002. PMC 4717490. PMID 25676371.
- ↑ Lang F, Lang E, Föller M (October 2012). "Physiology and pathophysiology of eryptosis". Transfusion Medicine and Hemotherapy. 39 (5): 308–314. doi:10.1159/000342534. PMC 3678267. PMID 23801921.
- ↑ Föller M, Huber SM, Lang F (October 2008). "Erythrocyte programmed cell death". IUBMB Life. 60 (10): 661–668. doi:10.1002/iub.106. PMID 18720418. S2CID 41603762.
- ↑ An X, Mohandas N (May 2008). "Disorders of red cell membrane". British Journal of Haematology. 141 (3): 367–375. doi:10.1111/j.1365-2141.2008.07091.x. PMID 18341630. S2CID 7313716.
- ↑ Coghlan A (19 August 2008). "First red blood cells grown in the lab". New Scientist. Retrieved 26 March 2023.
- ↑
"Researchers are trialing lab-grown blood transfusions: What to know". medicalnewstoday.com. MedicalNewsToday. 11 November 2022. Archived from the original on 15 November 2022. Retrieved 17 November 2022.
A team of researchers led by the National Health Service (NHS) Blood and Transplant unit recently launched the first clinical trial to transfuse lab-grown red blood cells into a live human.
- ↑ "Circular of Information for Blood and Blood Products" (PDF). American Association of Blood Banks, American Red Cross, America's Blood Centers. Archived from the original (PDF) on 30 October 2011. Retrieved 1 November 2010.
- ↑ Valeri CR (8 February 1996). "Frozen Red Cell Technology". In Sparacino L, Manning FJ (eds.). Blood Groups and Red Cell Antigens. National Academies Press (US) – via www.ncbi.nlm.nih.gov.
- ↑ "Swammerdam, Jan (1637–1680)", McGraw Hill AccessScience, 2007. Accessed 27 December 2007.
- ↑ "Max F. Perutz – Biographical". NobelPrize.org. Retrieved 23 October 2018.
- ↑ Pappas S (2 May 2012). "'Iceman' mummy holds world's oldest blood cells". Fox News. Retrieved 2 May 2012.
External links
- Blood Groups and Red Cell Antigens by Laura Dean. Searchable and downloadable online textbook in the public domain.
- Database of vertebrate erythrocyte sizes.
- Red Gold, PBS site containing facts and history

._Natuurkundige_te_Delft_Rijksmuseum_SK-A-957.jpeg.webp)